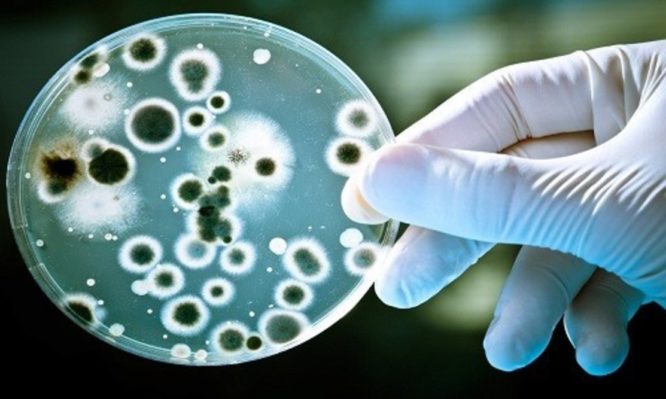

Ένας σχεδόν άτρωτος ιός γίνεται επιστημονικό εργαλείο για την αντιμετώπιση ασθενειών
Ο ιός SIRV2 δικαιωματικά μπορεί να χαρακτηρισθεί «πολύ σκληρός για να πεθάνει» αφού καταφέρνει και μολύνει έναν μικροοργανισμό, τον Sulfolobus islandicus, που ζει σε ένα από τα πιο αφιλόξενα περιβάλλοντα στην Γη: τις όξινες θερμοπηγές της Ισλανδίας όπου η θερμοκρασία αγγίζει τους 79,4°C (175°F). Τώρα, ερευνητές από το Πανεπιστήμιο της Βιρτζίνια ανακάλυψαν εκπληκτικές ομοιότητες μεταξύ του SIRV2 και βακτηριακών σπόρων που επιβιώνουν σε αντίξοες συνθήκες και ευθύνονται για φρικτές ασθένειες που θεραπεύονται δύσκολα όπως ο άνθρακας.
Όπως φαίνεται, το μυστικό αυτού του σχεδόν άτρωτου ιού είναι η δομική μορφή που δίνει στο DNA του –μια μορφή που οι ειδικοί πίστευαν ότι υφίσταται μόνο υπό εργαστηριακές, μη βιολογικές συνθήκες, όταν το DNA είναι αφυδατωμένο ή ξηρό. Ο συγκεκριμένος βιολογικός μηχανισμός όμως προστατεύει το DNA από θερμότητα μέχρι την αφυδάτωση και την υπεριώδη ακτινοβολία, αποτελώντας έτσι μια πραγματική «πανοπλία».
Η αποκάλυψη του μηχανισμού αντίστασης του εν λόγω ιού μπορεί να χρησιμεύσει στο «πακετάρισμα» DNA για ειδικές γονιδιακές θεραπείες, τονίζει ο Edward H. Egelman του UVA Department of Biochemistry and Molecular Genetics. Επιπροσθέτως, η κατανόηση πώς λειτουργούν τα βακτηριακά σπόρια «μας δίνει ενδεχομένως νέες ικανότητες για να τα καταστρέψουμε» λέει χαρακτηριστικά.
Βέβαια, το ξεκλείδωμα των μύχιων μυστικών του SIRV2 κατέστη δυνατό μόνο χάρη στην ισχύ του νέου ηλεκτρονιακού μικροσκοπίου Titan Krios του Πανεπιστημίου. Μονωμένο με τόνους τσιμέντου για την σταθερότητα που απαιτείται κατά την ανάλυση βιολογικών δειγμάτων με λεπτομέρεια αδύνατη μέχρι πρότινος, το τεράστιο μικροσκόπιο είναι ένα από τα λίγα του είδους του στον κόσμο.
Αλέξανδρος Θεολόγου







